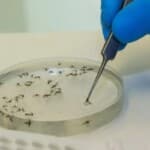
Fonte: Flávio Carvalho, Fiocruz

Oropouche: sintomas, formas de transmissão e prevenção
Ministério da Saúde
Vacina do Instituto Butantan mostra 89% de proteção contra dengue grave
Instituto Butantan
DESTAQUES
INOVAÇÃO
Estudo aborda vigilância genômica do vírus Oropouche no Brasil
4 setembro 2024
Fiocruz
Desenvolvimento do Kit Molecular Oroupoche/Mayaro começou há cerca de um ano.
Leia mais
Pesquisadores desenvolvem tecnologia para testar diferentes aditivos de vacinas e criar respostas imunológicas mais fortes
8 agosto 2024
Universidade Stanford
Curativo com nanopartículas combate infecção e melhora a cicatrização de feridas
1 agosto 2024
Agência FAPESP
Inteligência Artificial identifica infecção semelhante à febre tifoide resistente a medicamentos a partir de imagens de microscopia em questão de horas
12 julho 2024
Universidade de Cambridge
CIÊNCIA
Oropouche: sintomas, formas de transmissão e prevenção
21 agosto 2024
Ministério da Saúde
Vacina do Instituto Butantan mostra 89% de proteção contra dengue grave
16 agosto 2024
Instituto Butantan
Vírus Epstein-Barr na saliva de pacientes com cirrose dá pistas sobre queda imunológica
12 agosto 2024
Jornal da USP
RNAs circulares: a nova fronteira na pesquisa do câncer
4 agosto 2024
Universidade Flinders
Pesquisadores revelam como bactéria auxilia na cicatrização de feridas diabéticas crônicas
29 julho 2024
Escola de Medicina da Universidade da Pensilvânia
Instituto Butantan: alta tecnologia na fabricação de soros hiperimunes
23 julho 2024
Instituto Butantan
NEGÓCIOS E PARCERIAS
Consórcio global deve impulsionar a próxima geração de vacinas
16 março 2024
Imperial College de Londres
Takeda, Universidade de Dundee e Universidade de Cambridge são parceiros na luta contra a demência
17 fevereiro 2024
Universidade de Dundee
Lorice Scalise, farmacêutica formada pela Unesp, é a primeira latino-americana a presidir a Roche Farma Brasil
13 setembro 2023
Jornal da Unesp
LIVROS GRATUITOS
Atenção farmacêutica: um cuidado essencial
Editora UFPE
(2021)
Gestão e vigilância do sangue e de medicamentos
Editora UFPR
(2022)
Detecção precoce do câncer
INCA/Ministério da Saúde
(2021)
Citomorfologia do sangue periférico
Atena Editora
(2021)
MANUAIS GRATUITOS
Gestão do Cuidado Farmacêutico na Atenção Básica
Ministério da Saúde
(2019)
Uso racional de medicamentos
Editora da UFOP
(2019)
Política e Programa Nacional de Plantas Medicinais e Fitoterápicos
Ministério da Saúde
(2016)
Rede t4h: + conhecimento, + networking
O Portal farma t4h é um dos portais especializados da Rede t4h, com foco em Ciências Biológicas, Biomédicas e Farmacêuticas, Saúde e Tecnologias. Concentrando notícias, conteúdos de alto valor agregado e uma rede profissional e de estudantes, o farma t4h foi desenvolvido para facilitar o conhecimento e a interação entre profissionais e pessoas interessadas nas várias áreas relacionadas a Fármacos, Medicamentos, Biologia Celular e Molecular, Genômica e Proteômica, Bioquímica, Biotecnologia, Diagnóstico e Medicina Personalizada.
Participe. Publique. Compartilhe.
[wpv-post-body view_template=’footer_farma’]